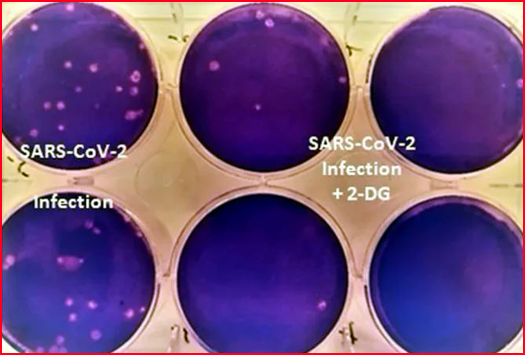

حید رآباد کی ما یا ناز فار ما کمپنی ڈاکٹر ریڈیس لیاب کے تعاون سے تجر بات
ڈرگس کنٹرولر جنرل آف انڈیا کی اجازت .۔جلد ہی دستیاب
حید رآباد 10 / مئی
(زین نیوز )
zainnews.net
کورونا کے تیزی سے پھیلنے کے ما حول میں ڈی آر ڈی او نے عوام کو ایک امید کی کر ن د کھائی ہے ۔اب کورونا متا ثر ین کے جلد صحتیاب ہو نے اور آکسیجن لگا نے کی ضرورت کو کم کر نے کے لئے 2-DG دوا عنقر یب مارکٹ میں دستیاب ہو گی
واضح ر ہے کہ کوویڈ 19 وائر س پر قابو پا نے کے لئے نئی دوا تیارکر نے کا ڈی آر ڈی او( ڈیفنس ر یسرچ اینڈ ڈیو لپمنٹ آر گنازئشن) چیر مین ستیش ر یڈی نے انکشاف کیا ۔انہوں نے آج میڈ یا کے نمائندوں سے بات چیت کر تے ہو ئے کہا کہ ملک میں کورونا کی دوسری لہر اپنے شباب پر ہے اور اس پر قابو پا نے کے لئے ابھی تک انجکشن کی شکل میں ویکسن ہی دستیاب ہوا ہے ۔
جبکہ ڈی آر ڈی او اوراس سے ملحقہ ادارے نیو کلیر میڈ یسن اینڈ الائیڈ سائنس نے اپنی مشتر کہ جد و جہد اور تحقیق سے پائوڈر ( سُفوف ) کی شکل میں ایک دوا تیار کی ہے ۔ جوکورونا کے مر یضوں کے لئے 2-DG کے مماثل کا م کر ے گی ۔انہوں نے بتا یا کہ کورونا کی عام ادویات کو ملاکر ہی سفوف کی شکل میں نئی دوا تیار کی گئی ہے
۔ انہوں نے بتا یا کہ سفوف کی تیاری کے بعد حید رآباد سی سی ایم بی میں اس کی تمثیلی مشق اور تجر بہ کیا گیا ۔ حید رآباد کی ما یا ناز فار ما کمپنی ڈاکٹر ریڈیس لیاب کے تعاون سے تجر بات کئے گئے اور یہ نتیجہ اخد کیا گیا کہ کورونا سے بچائو میں یہ سفوف( پا ئوڈر) مکمل محفوظ ہے اور اسکے کو ئی ذ یلی اثرات بھی نہیں ہیں ۔
جن کورونا مر یضوں پر یہ پا ئوڈر کو تجر باتی طور پر استعمال کیا گیا انہیں 4 تا 5 دنوں میں کوویڈ منفی ر پورٹ آئی ہے۔ گذشتہ سال ڈسمبر تا امسال مارچ تک ملک کی مختلف ریاستوں کے 220 کورونا متا ثر ین کو یہ پائوڈر کے ذ ریعہ علاج کر کے آز مایا گیا۔ جن میں 42% مر یض دوا استعمال کر نے کے اندرون تین دنوں میں ہی صحت مند ہو گئے۔تاہم آکسیجن اور ویکسن کی قلت اور بستروںکی کمی کے خوفناک ماحول میںڈی آر ڈی او کا یہ سفوف ایک متبادل ہو گا ۔
یہ بھی پڑھیں : بی جے پی کارپوریٹر کی بیٹی کی کورونا انفیکشن سےموت
انہوں نے بتا یا کہ کورونا کی معمولی علا متیں پا ئی جا نے والے اور کو رونا سے متاثر ہو کر تشویشناک صورتحال اختیار کر نے والے افراد تک کے لئے یہ کار آ مد ہے ۔ انہوں نے بتا یا کہ کلینکل ٹرائیل میں بھی اس دوا کو کورونا مر یضوں کے لئے کار آ مد پا یا گیا ہے۔ اور اسکے ہنگامی استعمال کے لئے ڈرگس کنٹرولر جنرل آف انڈیا نے اجازت بھی فرا ہم کی ہے ۔البتہ انہوں نے مر یضوں کو مشورہ د یا کہ وہ ڈاکٹر کے مشورے سے ہی یہ دوا کا استعمال کر یں۔
یہ پائوڈر پا نی میں دال کر استعمال کر نا ہوگا اور یو میہ تین مر تبہ استعمال کر نا کا فی ہو گا ۔انہوں نے بتا یا کہ اس پا ئوڈر کے استعمال سے جسم میں قوت مدا فعت میں اضا فہ ہو گا ۔خصوصاََ65 سال سے زائد عمر والوں کے لئے یہ دوا انتہائی مفید ہو گی ۔انہوں نے بتا یا کہ ابھی یہ دوا عوامی تقسیم کے لئے اجازت کے آخر ی مر حلہ میں ہے اگر یہ مل جا ئے تو اگلے دو تین ہفتوں میں عوام کے لئے دستیاب ہو گی ۔